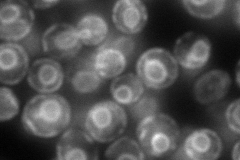
YLR066W
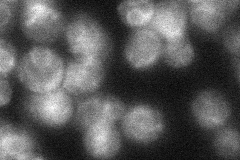
YLR066W
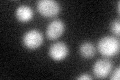
YLR066W

View description
Subunit of signal peptidase complex (Spc1p, Spc2p, Spc3p, Sec11p), which catalyzes cleavage of N-terminal signal sequences of proteins targeted to the secretory pathway; homologous to mammalian SPC22/23
Localization:
Intensity:
Fold change:
Significance:
-
C’ GFP library in SD

below threshold13.86 -
N' NOP1pr-GFP in SD

ER120.983 -
N' TEF2pr-mCherry in SD
ER148.742 -
N' NATIVEpr-GFP in SD
ER36.8772 -
N' TEF2pr-VC and Cyto-VN in SD

below threshold26.3433 -
C’ GFP library in SD+DTT
cytosol16.461.18No -
C’ GFP library in SD+H2O2

cytosol15.261.1No -
C’ GFP library in Starvation Media

cytosol17.081.23No -
C’ GFP library on the background of Pup2-DaMP

below threshold -
C’ GFP library on the background of CCT mutant

below threshold13.9051.00225No
